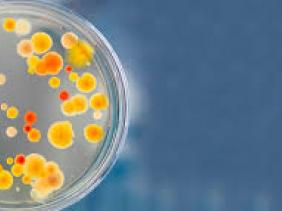

La biotechnologie est appelée à devenir un des nouveaux piliers de notre économie. Maurice devrait bientot accueillir les opérations de la firme HI TECH, cette entreprise qui propose des solutions de recherches au niveau mondial entend ouvrir une branche à Maurice. Salim Ismael, le CEO du parc SOCOTA PHEONICIA est d'avis que notre pays dispose de la matière grise pour permettre de telles avancées, il ajoute que notre région est riche en matière première.







